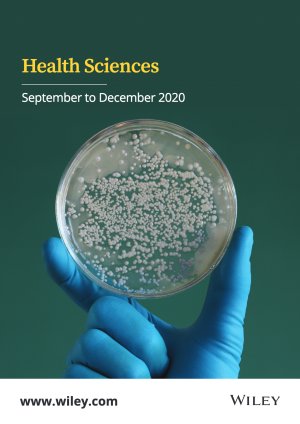

- For Libraries/Librarians
- For Channel Partners & Training Providers
- Business & Economics
- Chemistry
- Dummies®
- Engineering & Computing
- Finance & Accounting
- For Young(er) Audience
- General Consumer
- Medical & Food Science
- Hospitality & Culinary
- Humanities
- Life & Earth Science
- Math, Stats & Physics
- Retail Catalogs
- Social Science, Education & Psychology
- Test Preps & Certifications
- Veterinary Science
- For Faculty
- Contact a Sales Representative